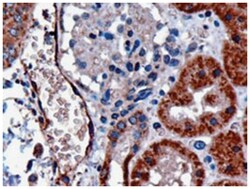
DARC, Goat, Polyclonal Antibody, Abnova 100 &mu;g | Buy Online | Abnova | Fisher Scientific

Learn More
DARC, Goat, Polyclonal Antibody, Abnova™
Beschreibung
The protein encoded by this gene is a glycosylated membrane protein and a nonspecific receptor for several chemokines. The encoded protein is the receptor for the human malarial parasites Plasmodium vivax and Plasmodium knowlesi. Polymorphisms in this gene are the basis of the Duffy blood group system. Two transcript variants encoding different isoforms have been found for this gene. [provided by RefSeq
Spezifikation
Spezifikation
| Antigen | DARC |
| Anwendungen | ELISA, Flow Cytometry, Immunohistochemistry (PFA fixed), Western Blot |
| Klassifikation | Polyclonal |
| Konzentration | 0.5 mg/mL |
| Konjugat | Unconjugated |
| Beschreibung | Goat polyclonal antibody raised against synthetic peptide of DARC. |
| Verdünnung | ELISA (1:16000) Western Blot (0.1-0.3 ug/mL) Immunohistochemistry (3 ug/mL) The optimal working dilution should be determined by the end user. |
| Zusammensetzung | In Tris saline, pH 7.3 (0.5% BSA, 0.02% sodium azide) |
| Gen | DARC |
| Gen-Zugriffsnummer | NP_002027.2 |
| Mehr anzeigen |
For Research Use Only
Indem Sie auf Absenden klicken, erklären Sie sich damit einverstanden, dass Fisher Scientific sich mit Ihnen in Verbindung setzen kann, um Ihr Feedback in diesem Formular zu bearbeiten. Wir werden Ihre Informationen nicht für andere Zwecke weitergeben. Alle bereitgestellten Kontaktinformationen werden in Übereinstimmung mit unserer Datenschutzrichtlinie aufbewahrt. Datenschutzrichtlinie.